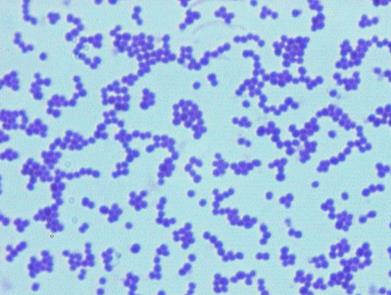

资讯
疾病资讯
-
来源:tmsdzafd 2017年12月16日
一个朋友在例行检查中,被诊断为解脲支原体病毒,医生说可能导致不育。是什么原因导致这种疾病,为什么会导致不能怀孕呢?为未来的快乐做准备是一件大事,因此你和你的
-
来源:tmsdzafd 2017年12月18日
解脲支原体是性传播的,支原体种类的主要问题是它们缺乏细胞壁,使得它们抵抗通常靶向该区域的抗生素。它们也是一些可以自己繁殖的细菌,这使得它们更难以被光学显微
-
来源:tmsdzafd 2017年12月16日
名称:解脲支原体同义词或交叉参考:非淋菌性尿道炎(NGU),非特异性尿道炎(NSU),生殖器支原体。特征:1937年首次在人体中发现,支原体科是一种独特的多形性原核生物,在
-
来源:tmsdzafd 2017年12月16日
解脲支原体感染对男性精子分泌有影响吗生殖器脲霉素(解脲支原体和小脲枝菌)和支原体(生殖支原体和人型支原体)是在生殖器感染和男性不育中起病因作用的潜在致病物
-
诗诗怀孕打破吴奇隆患男性“隐疾”传闻 女性输卵管堵塞也能导致不孕
来源:justone 2017年12月16日
娱乐圈里的分分合合,让吃瓜群众操碎了心,大家关注的吴奇隆和刘诗诗这对娱乐圈的金童玉女在婚后,却一直没有传出刘诗诗怀孕的消息。早年前,吴奇隆与前妻离婚就曾被
-
来源:tmsdzafd 2017年12月15日
盆腔炎(PID)是一种生殖器官感染的炎症,感染在下腹部,包括输卵管,输卵管卵巢,子宫颈,和子宫。几种不同类型的细菌可以导致PID,包括导致相同的细菌性传播感染淋病和
-
来源:tmsdzafd 2017年12月15日
厕所感染,通常被一些人称为厕所疾病,是女性经历不适,如灼热,瘙痒,从阴道进来的不愉快或恶臭。大多数女士会发誓,他们开始使用公共厕所后感到不舒服。不管如何看待
-
来源:tmsdzafd 2017年12月15日
未经治疗的性传播疾病可能导致女性患有严重的盆腔炎。通常来说患病的原因有以下几点:1.私生活紊乱;2.之前有过盆腔炎;3.房事活跃,年龄在25岁以下;4.冲洗不当;怎样
-
来源:tmsdzafd 2017年12月16日
盆腔炎是女性生殖系统感染,包括卵巢,输卵管,子宫和子宫颈。一般由性传播感染引起盆腔炎,如淋病和衣原体感染。10%至20%的淋病感染妇女和20%至40%的宫颈衣原体感染
-
来源:justone 2017年12月15日
结核性盆腔炎的临床表现是不一样的,因人而异,有些患者在患病期间是没有什么症状表现的,但是有的患者病情则较为明显。所以,要重视自己的健康,在进行妇科检查以后一
最热资讯
最新资讯
-
对于处于更年期的女性来说,睡眠是一项需要改善的问题,...
-
失眠是大多数人都会有的一种经历,因为它是一种很常见的...
-
咖啡使我们非常熟悉的一种饮品,对于白领们来说喝咖啡是...
-
许多女性朋友都有这么一个烦恼,为什么我每天都运动可还...
-
年龄是许多女人很在意的,几乎所有的女人都会介意自己的...
-
有人会说中年女人非常有魅力,又有的人觉得中年女人人老...
-
熬夜在许多人眼里,并不是一件可怕的事情,反而是一件很...
-
从现代医学角度讲,引起老寒腿的原因是有许多的。很多人...
-
在中老年人中肥胖也是很常见的,肥胖经常会给我们的生活...
-
在我们的生活中有的人他并不胖,有的人喝水也会长胖,而...